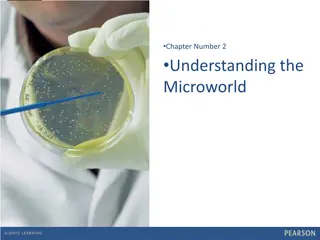

Foodborne Illness: Causes and Symptoms
Foodborne illnesses are diseases transmitted to humans through contaminated food, causing symptoms like nausea, vomiting, stomach cramps, fever, and diarrhea. These illnesses are mainly caused by pathogenic microorganisms such as bacteria, viruses, and parasites, often spread through mishandling of food. Bacteria, viruses, and parasites are classified based on their shapes and can lead to various symptoms and health issues when ingested through contaminated sources. Proper food handling and cooking practices are essential to preventing these illnesses.
Download Presentation

Please find below an Image/Link to download the presentation.
The content on the website is provided AS IS for your information and personal use only. It may not be sold, licensed, or shared on other websites without obtaining consent from the author.If you encounter any issues during the download, it is possible that the publisher has removed the file from their server.
You are allowed to download the files provided on this website for personal or commercial use, subject to the condition that they are used lawfully. All files are the property of their respective owners.
The content on the website is provided AS IS for your information and personal use only. It may not be sold, licensed, or shared on other websites without obtaining consent from the author.
E N D
Presentation Transcript
FOOD SAFETY SLEUTHS Photo Credit CDC Amanda Mills
What is a foodborne illness? A disease carried to humans by food Symptoms include nausea, vomiting, stomach cramps, fever, and diarrhea Photo Credit CDC
What causes foodborne illness? Mostly caused by pathogenic microorganisms Bacteria Viruses Parasites Photo Credit CDC/ Cynthia Goldsmith Often spread by mishandling food. Invisible to the naked eye.
Bacteria Single-celled organisms. Most are harmless but those that cause illness are pathogenic. Thrive in warm, damp places. Can double in number every 10 30 minutes.
Bacteria are classified by 3 main shapes: Bacillus rod shape Cocci spherical shape Spirilla spiral shape File:Bacillus subtilis R0179.jpg File:ARS Campylobacter jejuni.jpg Bacteria
One example of a type of bacteria that commonly causes illness is Salmonella Sources include contaminated meat, milk, juice, cheese, and veggies. Reptiles, amphibians, and birds can also carry the bacteria. Symptoms diarrhea, fever, stomach cramps, vomiting for 4-7 days. Bacteria
Viruses - smallest forms of life. Cannot reproduce outside living host cell. Hepatitis A is an example of a virus that causes liver disease. Sources raw or undercooked shellfish, raw produce, contaminated water, fecal material from infected person Symptoms diarrhea, dark urine, jaundice, fever, nausea, loss of appetite. Viruses
Parasites - tiny organisms that require a host to live. Example of a parasite that affects many people in the U.S. is Toxoplasma gondii. Sources contaminated raw meat, cutting boards, feces from infected cats, contaminated water Symptoms enlarged lymph nodes, headache, muscle pain, fever, sore throat, eye disease Parasites
PREVENTION Prevent foodborne illness from viruses, bacteria, and parasites by: Clean: Before eating or preparing food, wash hands for at least 20 seconds, utensils, cookware, and surfaces with soap and water. Rinse fruits and vegetables with water. 1. Separate: Use separate cutting boards and plates for raw produce, meat, poultry, seafood, and eggs. 2. Cook: Cook food to at least 140 F. The danger zone at which bacteria multiply rapidly is from 40 F to 140 F 3. Chill: Refrigerate perishable foods within two hours or less. Set refrigerator between 40 F and 32 F, and freezer 0 F or below. Thaw or marinate foods in the refrigerator or microwave. Throw food out that is past its expiration date! 4.
Now you know what it takes to be a food safety superstar File:Superstar (3775824255).jpg 1. Clean 2. Separate 3. Cook 4. Chill Write a song or rhyme about the food safety steps. File:Thumbs up by Wakalani.jpg